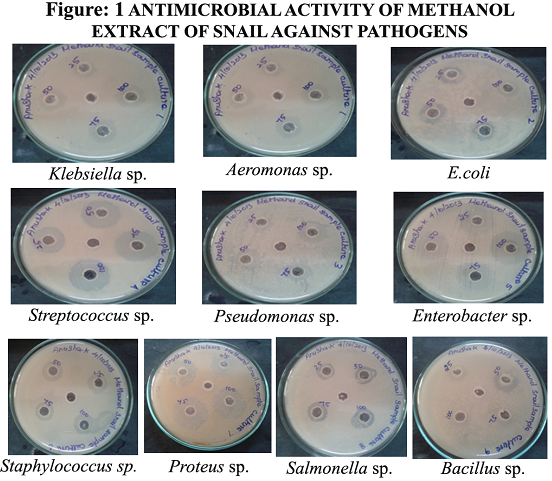
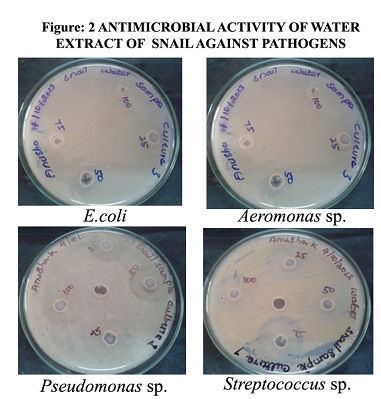
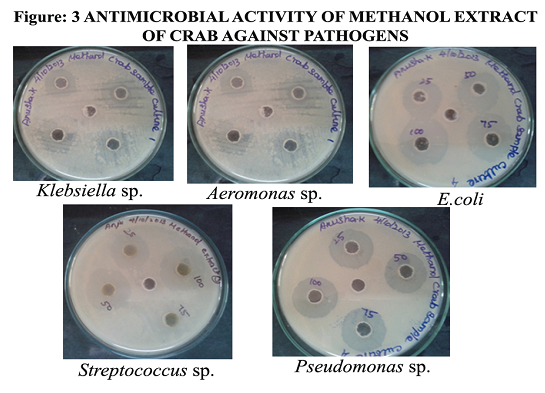
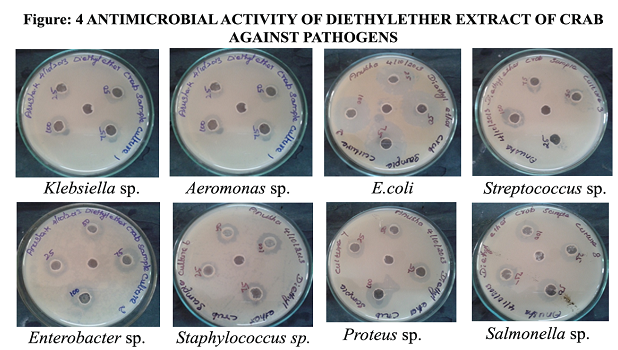
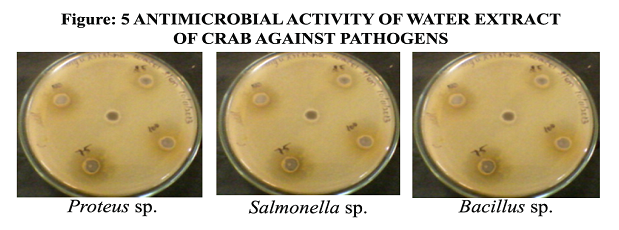

1Department of Microbiology, Udaya College of Arts and Science, Vellamodi, 2Department of Biotechnology, Udaya School of Engineering, Vellamodi, 3Department of Marine Science, SDMRI, Tuticorin.
Email: packia_3779@yahoo.co.in
Received: 16 Sep 2014 Revised and Accepted: 20 Oct 2014
ABSTRACT
Objective: The present study was undertaken to characterize antimicrobial molecules from the fresh water snail and crab.
Methods: Collection of haemolymph, preparation of extracts, antimicrobial activity, TLC analysis, SDS PAGE analysis.
Results: The result of the present investigation reported that the fresh water snail (Pomacea insularium) and crab (Callinectes sapidus) having remarkable antimicrobial activity in methanol, di-ethyl ether and water extracts. Antimicrobial activity was high in di-ethyl ether extracts of the snail against Streptococcus sp. (37.16±0.76 mm) and methanol extract of crab against E. coli (32.16±0.28 mm). The MIC of extracts ranges between 5 µl to 30 µl methanol extract of both snail and crab inhibited the growth of organisms at very low concentration. Biomolecules from the extract was separated by TLC. The molecular mass of the peptide was determined by SDS PAGE. Peptides from snail and crab haemolymph were ranges in 9 to 110 and 40 to 100 kDa respectively.
Conclusion: The present findings suggest that fresh water crab and snail having good antimicrobial activity against pathogenic microbes. Therefore they can be used to treat many pathogenic infections.
Keywords: Antimicrobial, Innate immunity, Haemolymph, TLC, SDS PAGE, Snail, Crab.
INTRODUCTION
Ocean offers a large biodiversity of fauna and flora which is estimated to be over 5, 00,000 species or more than double of the land species [1]. This rich diversity of marine organisms assumes a great opportunity for the discovery of new bioactive substances. Thus the marine environment is an exceptional reservoir for bioactive natural products, many of which exhibit structural features that are not found in terrestrial natural products [2]. From 1960's approximately 6,500 bioactive compounds have been isolated from the marine organisms [1]. Antimicrobial peptides are important in the first line of the host defence system of many animal species [3]. Their value in innate immunity lies in their ability to function without either high specificity or memory. The screening of marine bivalves for therapeutic drugs is of greater interest for the scholars nowadays. In recent years, it has been widely recognized that many organisms use Antimicrobial peptides (AMPs) as part of their host defence system against the invasion of microorganisms [4, 5].
Mollusks are a large phyllum of invertebrate animals and have many representatives in the marine and estuarine ecosystem namely slugs, whelks, clams, mussels, oysters, scallops, squids and octopus. Because of lacking adaptive immunity, mollusks are solely dependent on physical barriers and the innate immune system for protection against a broad range of pathogenic agents [6]. The presence of antimicrobial activity in the mucus of the snail (not AMPs) was reported as early as the1980s [7, 8]. Thousands of bioactive compounds identified in marine organisms revealed that sea creatures constitute a large reservoir for pharmacologically active drugs. In this research, we have collected the freshwater snail and crab from the paddy field to collect the haemolymph by single bleed collection method. Methanol, di- ethyl ether and water extract of snail and crab was prepared for the antimicrobial efficacy and TLC. The molecular mass of the antimicrobial peptide was determined by SDS PAGE.
MATERIALS AND METHODS
Collection of animals
The fresh water snail (Pomacea insularium) and crab (Callinects sapidus) were collected from paddy field in kuzhithurai, Kanyakumari District, Tamilnadu, India., using cast net. Healthy animals of different sizes were used throughout for experimental purpose and each animal was subjected to single bleed collection. Snails (Pomacea insularium) were placed in glass bottles, filled with water from the same habitat and were brought to the laboratory in a cooler containing ice to avoid overheating during transportation. Snails were identified according to the morphological features of the shell using keys of Mendis and Ferando[9] and Naggs and Raheem[10]. The animals were carefully removed from the shell. The crabs (Callinects sapidus) in uniform size, good health and free from disease was collected. The weight of the collected crabs was ranging between 100-120g. After reaching the laboratory, the crabs were immersed in 5 ppm formalin (prophylactic dip) for 15 min and acclimated to the laboratory conditions.
Extraction of the animal tissues
The extraction method was followed by Chellaram et al. [11]. The freshly collected mollusk tissues each 15g in dry weight were soaked in methanol, di-ethyl ether and water and maintained for 3days. The extracts were filtered through Whatman No.1 filter paper and concentrated by evaporation to give a dark brown gummy mass. The resultant residues were stored at 4°C for further analysis.
Microbial strains used
Antibacterial activity of crab and snail was determined against 10 different bacterial strains viz, Klebsiella sp., Aeromonas sp., E. coli, Streptococcus sp., Pseudomonas sp., Enterobacter sp., Staphylococcus sp., Proteus sp., Salmonella sp. And Bacillus sp.
Preparation of inoculum
Strains of 10 bacterial cultures were used in this study. Identical colonies were isolated and sub cultured in 2 ml of nutrient broth for 4 hrs at 37oC. Standardization of the inoculum was made by preparing a McFarland standard and compared with the turbidity of the inoculum.
Antimicrobial activity
Muller Hinton agar plates were used for susceptibility testing by the agar well diffusion technique. Antibacterial activity was carried out by using standard well diffusion method [12, 13]. 100 μL of diluted bacterial suspension (5 x 106 cfu /ml) of test bacterial strains were swabbed on the surface of Hinton agar. After 5 min, varying concentration (25 µl, 50 µl, 75 µl, and 100 µl) from 10 mg/ ml stock concentration of extract was added and the plates were incubated at 37oC for 24 hrs. The diameters of the zone of inhibition of growth (including 4 mm diameter of well itself) was measured with the help of a scale. More than 12 mm in the measurement is sensitive zones, between 4 to 12 mm is moderately sensitive and zones less then 4 mm is resistant.
MIC determination by broth dilution method
The MIC of the organic solvent extracts of crab and snail were determined using broth dilution method. From the stock solution of 10mg/ml of extract, various concentrations of extracts (5 µl, 10 µl, 15 µl, 20 µl, 30 µl, 35 µl and 40 µl) was added in 5 ml of broth inoculated with 100 µl of culture (5x106 cfu/ml). The tubes were incubated at 37ºC for overnight with shaking and the highest dilution in which there was no growth was recorded as MIC.
Isolation of compounds from the crude extract by TLC
The extract which showed best activity against the test organisms were used in TLC for the separation of bioactive compounds. 5 µl of the crude extract was spotted on a TLC plate coated with silica gel (thickness 0.5 mm), dried and kept in the saturated twin trough chamber containing Diethyl-ether: Methanol: Water in the ratio 3:1:1(v/v) as a mobile phase and developed up to 6 cm length. The plate was removed and dried. After drying, the TLC plates were sprayed with ninhydrin reagent.
SDS page
50 µl of sample was mixed with 50 µl of SDS sample buffer, boiled for 30 minutes and loaded on gel. The samples were run at a constant voltage of 50v through the stacking gel and at100V through the separating gel until the dye reached the bottom of the plate. The gel was removed from the apparatus and stained with coomassie brilliant blue for about 3 to 4 hours. After destaining, the gel was viewed for clear bands.
RESULTS
The snail and crab were identified as Pomacea insularium (snail) and Callinectes sapidus (crab) based on their morphological and physiological characteristic feature. Bioassay of all extracts of snail and crab using standard agar well diffusion assay showed that methanol, di-ethyl ether, water extract appeared to be active against all test organisms. In fact, inhibition zones were determined by radial diffusion assay.
Antimicrobial activity of methanol extract of snail against pathogen
The highest antimicrobial activity of methanol extract of snail against Streptococcus sp. Was observed as 27.83±0.76 mm zone of inhibitions followed by E. coli (22.16±0.28 mm) and Bacillus sp. (21.73±0.64 mm). Next to that, best activity was registered against Klebsiella sp. and Salmonella sp. (20.0±0.5 mm). The activity showed against Aeromonas sp. Was 19.0±0.5 mm and the least activity was observed in Proteus sp. (17.16±0.76 mm) (Fig 1). The result was reported in table 1.
Table 1: Antimicrobial activity of methanol extract of snail against pathogens
Organisms |
Zone of inhibition (mm) Concentration of extract (µl) |
|||
25 |
50 |
75 |
100 |
|
Klebsiella sp. |
11.83±0.76 |
15.16±0.28 |
17.33±0.57 |
20.0±0.5 |
Aeromonas sp. |
10.0±0.5 |
14.83±0.76 |
14.83±0.28 |
19.0±0.5 |
E. coli |
15.0±0.5 |
17.16±0.28 |
19.83±0.76 |
22.16±0.28 |
Streptococcus sp. |
22.16±0.28 |
25.0±0.5 |
26.0±0.5 |
27.83±0.76 |
Pseudomonas sp. |
23.16±0.76 |
24.16±0.28 |
25.83±0.76 |
20.83±0.76 |
Enterobacter sp. |
13.83±0.76 |
16.16±1.25 |
17.16±0.76 |
18.16±0.28 |
Staphylococcus sp. |
22.0±0.5 |
25.83±0.76 |
27.0±0.5 |
28.16±0.28 |
Proteus sp. |
13.0±0.5 |
16.0±0.5 |
17.83±0.28 |
17.16±0.76 |
Salmonella sp. |
12.16±0.28 |
15.16±0.28 |
16.33±0.57 |
20.0±0.5 |
Bacillus sp. |
15.5±0.5 |
16.5±0.5 |
17.83±0.76 |
21.73±0.64 |
Fig. 1: Antimicrobial activity of methanol extract of snail against pathogen
Antimicrobial activity of di-ethyl ether extract of snail against pathogen
The highest antimicrobial activity of di-ethyl ether extract of snail against Streptococcus sp. was observed as 37.16±0.76 mm zone of inhibition and was followed by Pseudomonas sp. (31.83±0.76 mm). Next to that, best activity was seen in Staphylococcus sp. (30.5±0.86 mm) and the activity determined against Enterobacter sp. and Salmonella sp. was 29.83±0.76 mm zone of inhibition and the least activity was observed in Proteus sp. (21.66±0.57 mm). The result was given in table 2.
Antimicrobial activity of water extract of snail against pathogen
The highest antimicrobial activity of water extract of snail against Proteus sp. was observed as 30.16±0.76 mm zone of inhibitions followed by Streptococcus sp. (29.0±0.5 mm) and next to that, the least activity was seen in Aeromonas sp. (25.16±0.28), Staphylococcus sp., and Bacillus sp. (24.83±0.76 mm). The activity against Pseudomonas sp. was 21.83±0.76 mm zone of inhibitions and the least activity was observed in Salmonella sp. (19.0±0.5 mm) (Fig 2; table 3).
Antimicrobial activity of methanol extract of crab against pathogen
The highest antimicrobial activity of methanol extracts of crab against E. coli was observed as 32.16±0.28 mm zone of inhibition followed by Pseudomonas sp. (30.0±0.5) and Streptococcus sp. (29.5±0.5 mm) and next, the activity was recorded in Staphylococcus sp. (27.0±0.5 mm) and the activity showed against Klebsiella sp. and Bacillus sp. was 19.83±0.28 mm of zone of inhibition and the least activity was observed in Aeromonas sp. (18.0±0.5 mm) (Fig 3). The result was reported in table 4.
Fig. 2: Antimicrobial activity of water extract of snail against pathogen
Table 2: Antimicrobial activity of di-ethyl ether extract of snail against pathogen
Organisms |
Zone of inhibition (mm) Concentration of extract (µl) |
|||
25 |
50 |
75 |
100 |
|
Klebsiella sp. |
14.83±0.28 |
19.83±0.76 |
20.16±0.76 |
25.16±0.76 |
Aeromonas sp. |
9.83±0.76 |
15.16±0.28 |
19.83±0.76 |
26.83±0.76 |
E. coli |
19.83±0.28 |
21.66±0.28 |
24.66±0.28 |
30.33±0.57 |
Streptococcus sp. |
19.83±0.76 |
24.83±0.76 |
26.83±0.76 |
37.16±0.76 |
Pseudomonas sp. |
25.16±0.28 |
27.16±0.76 |
29.83±0.76 |
31.83±0.76 |
Enterobacter sp. |
19.66±0.57 |
25.33±0.28 |
25.33±0.57 |
29.83±0.76 |
Staphylococcus sp. |
14.66±0.57 |
24.66±0.57 |
30.16±0.76 |
30.5±0.86 |
Proteus sp. |
15.33±0.57 |
17.16±0.28 |
18.83±0.76 |
21.66±0.57 |
Salmonella sp. |
14.83±0.76 |
20.16±0.28 |
25.0±0.5 |
29.83±0.76 |
Bacillus sp. |
9.5±0.5 |
14.66±0.28 |
19.5±0.5 |
20.33±0.57 |
Table 3: Antimicrobial activity of water extract of snail against pathogen
Organisms |
Zone of inhibition (mm) Concentration of extract (µl) |
|||
25 |
50 |
75 |
100 |
|
Klebsiella sp. |
15.16±0.76 |
15.83±0.76 |
18.16±0.28 |
20.33±0.57 |
Aeromonas sp. |
19.0±0.5 |
20.0±0.5 |
22.16±0.28 |
25.16±0.28 |
E. coli |
10.16±0.28 |
11.5±0.5 |
15.0±0.5 |
20.16±0.28 |
Streptococcus sp. |
20.16±0.28 |
25.0±0.5 |
27.16±0.76 |
29.0±0.5 |
Pseudomonas sp. |
15.0±0.5 |
17.16±0.28 |
19.16±0.28 |
21.83±0.76 |
Enterobacter sp. |
16.0±0.5 |
17.83±0.28 |
18.83±0.76 |
20.16±0.76 |
Staphylococcus sp. |
14.83±0.28 |
19.16±0.28 |
22.33±0.57 |
24.83±0.76 |
Proteus sp. |
22.0±0.5 |
24.83±0.28 |
28.0±0.5 |
30.16±0.76 |
Salmonella sp. |
14.0±0.5 |
15.83±0.76 |
16.83±0.28 |
19.0±0.5 |
Bacillus sp. |
19.83±0.76 |
20.83±0.76 |
23.16±0.28 |
24.83±0.76 |
Table 4: Antimicrobial activity of methanol extract of crab against pathogen
Organisms |
Zone of inhibition (mm) Concentration of extract (µl) |
|||
25 |
50 |
75 |
100 |
|
Klebsiella sp. |
15.16±0.28 |
16.0±0.5 |
17.0±0.5 |
19.83±0.28 |
Aeromonas sp. |
11.83±0.28 |
14.83±0.28 |
16.83±0.76 |
18.0±0.5 |
E. coli |
20.16±0.28 |
25.0±0 |
25.83±0.28 |
32.16±0.28 |
Streptococcus sp. |
23.0±0.5 |
28.33±0.28 |
28.66±0.28 |
29.5±0.5 |
Pseudomonas sp. |
22.16±0.28 |
25.0±0.5 |
27.16±0.28 |
30.0±0.5 |
Enterobacter sp. |
11.0±0.5 |
11.83±0.28 |
15.0±0.5 |
20.16±0.28 |
Staphylococcus sp. |
19.0±0.5 |
20.16±0.28 |
24.83±0.28 |
27.0±0.5 |
Proteus sp. |
14.83±0.28 |
16.0±0.5 |
17.16±0.28 |
18.0±0.5 |
Salmonella sp. |
14.83±0.76 |
17.16±0.28 |
18.0±0.5 |
18.66±0.28 |
Bacillus sp. |
14.16±0.28 |
15.0±0.5 |
16.83±0.76 |
19.83±0.28 |
Table 5: Antimicrobial activity of di-ethyl ether extract of crab against pathogen
Organisms |
Zone of inhibition (mm) Concentration of extract (µl) |
|||
25 |
50 |
75 |
100 |
|
Klebsiella sp. |
10.33±0.57 |
15.16±0.28 |
16.0±0 |
17.33±0.28 |
Aeromonas sp. |
15.53±0.76 |
17.16±0.28 |
18.83±0.28 |
21.16±0.28 |
E. coli |
14.66±0.57 |
17.16±0.28 |
20.0±0 |
22.16±0.28 |
Streptococcus sp. |
25.0±0.5 |
26.33±0.57 |
27.16±0.28 |
29.0±0.5 |
Pseudomonas sp. |
23.66±0.57 |
25.83±0.76 |
27.16±0.28 |
31.16±0.76 |
Enterobacter sp. |
15.0±0.5 |
15.83±0.76 |
17.0±0 |
29.0±0.5 |
Staphylococcus sp. |
22.83±0.28 |
26.0±0 |
27.83±0.28 |
30.33±0.57 |
Proteus sp. |
15.0±0.5 |
16.0±0.5 |
18.16±0.28 |
21.16±0.28 |
Salmonella sp. |
14.0±0.5 |
15.83±0.28 |
18.16±0.28 |
21.0±0.5 |
Bacillus sp. |
14.83±0.28 |
16.0±0.5 |
18.33±0.57 |
21.16±0.28 |
Fig. 3: Antimicrobial activity of methanol extract of carb against pathogen
Antimicrobial activity of di-ethyl ether extract of crab against pathogen
The highest antimicrobial activity of di-ethyl ether extract of snail against Pseudomonas sp. Was observed as 31.16±0.76 mm zone of inhibitions. The activity was followed to Staphylococcus sp. (30.33±0.57 mm). The antimicrobial activity evaluated in Streptococcus sp. and Enterobacter sp. was 29.0±0.5 mm and the activity showed against Salmonella sp was 21.0±0.5 mm of the zone of inhibition. The least activity was observed against Klebsiella sp. (17.33±0.28 mm) (Fig 4; table 5).
Fig. 4: Antimicrobial activity of diethylether extract of carb against pathogen
Antimicrobial activity of water extract of crab against pathogen
The highest antimicrobial activity of water extract of crab against Pseudomonas sp. (23.16±0.28) and Klebsiella sp. was observed as 22.83±0.28 mm zone of inhibition followed by Salmonella sp (22.16±0.28) and Aeromonas sp. (22 mm) and next to that, best activity was seen in Staphylococcus sp. (19.83±0.28 mm). The activity showed against Proteus sp was 19.16±0.28 mm of zone of inhibition and the least activity was observed in E. coli (15.83±0.76 mm) (Fig 5, table 6).
Table 6: Antimicrobial activity of water extract of crab against pathogen
Organisms |
Zone of inhibition (mm) Concentration of extract (µl) |
|||
25 |
50 |
75 |
100 |
|
Klebsiella sp. |
9.83±0.76 |
15.0±0.5 |
16.16±0.28 |
22.83±0.28 |
Aeromonas sp. |
11.83±0.76 |
18.0±0.5 |
21.16±0.28 |
22.0±0 |
E. coli |
7.83±0.76 |
10.16±0.76 |
12.16±0.28 |
15.83±0.76 |
Streptococcus sp. |
7.16±0.28 |
12.16±0.28 |
14.0±0.5 |
17.0±0 |
Pseudomonas sp. |
11.66±0.57 |
15.66±0.57 |
20.33±0.28 |
23.16±0.28 |
Enterobacter sp. |
13.83±0.28 |
15.5±0.5 |
16.0±0 |
18.33±0.57 |
Staphylococcus sp. |
8.0±0 |
12.16±0.28 |
16.5±0.5 |
19.83±0.28 |
Proteus sp. |
10.33±0.57 |
12.16±0.28 |
17.0±0.5 |
19.16±0.28 |
Salmonella sp. |
12±0.5 |
16.16±0.28 |
20.33±0.57 |
22.16±0.28 |
Bacillus sp. |
14.5±0.5 |
17.16±0.28 |
18.83±0.28 |
20.5±0.86 |
Table 7: MIC determination by broth dilution method for organic extracts of snail and crab
Organism |
Concentration of organic extracts of snail (µl) |
Concentration of organic extracts of crabl (µl) |
||||
Methanol extract |
Diethylether extract |
Water extract |
Methanol extract |
Diethyl ether extract |
Water extract |
|
Klebsiella sp. |
15 |
20 |
15 |
15 |
25 |
25 |
Aeromonas sp. |
20 |
25 |
10 |
20 |
15 |
20 |
E. coli |
10 |
10 |
20 |
10 |
15 |
30 |
Streptococcus sp. |
5 |
10 |
25 |
5 |
5 |
30 |
Pseudomonas sp. |
5 |
5 |
15 |
5 |
5 |
20 |
Enterobacter sp. |
15 |
10 |
15 |
20 |
15 |
15 |
Staphylococcus sp. |
5 |
20 |
15 |
10 |
25 |
30 |
Proteus sp. |
15 |
15 |
5 |
15 |
15 |
25 |
Salmonella sp. |
15 |
20 |
15 |
15 |
15 |
15 |
Bacillus sp. |
20 |
25 |
20 |
15 |
15 |
15 |
Fig. 5: Antimicrobial activity of water extract of carb against pathogen
MIC determination by broth dilution method
MIC values range from 5 µl to 20 µl for methanol extract of snail and crab against the bacterial pathogens. The organisms were inhibited in the range between 5 µl to 25 µl by the diethyl ether extract of snail and crab and aqueous extract of snail. The water extract of crab inhibited the growth of the organisms in the values ranges from 15 µl to 30 µl of concentration. Among all the extracts examined in this study, water extract showed the least activity; it inhibited the organisms in high concentration compared to other extracts (Table 7).
Thin- Layer Chromatography (TLC)
Thin-Layer chromatography profiling of the extract which showed best in bioactivity (methanol extract of crab and diethyl ether extract of snail) was done in solvent systems of diethyl ether: methanol: water (3:1:1 v/v). The plates developed in the solvent system showed the yellow spots when sprayed with ninhydrin indicating the presence of protein molecules in both experimental animals (fig 6).

Fig. 6: TLC of extracts
SDS-PAGE
The haemolymph of both the animals were subjected to SDS-PAGE to estimate the molecular weight of proteins present in it. The stained gel revealed that the haemolymph contained different types of proteins. In snail haemolymph, six different peptides were separated within the molecular weight ranges between 9 and 110 kDa whereas, in crab haemolymph, it showed four bands and the molecular weight of the peptide molecules ranges within 40 to 100 KDa (Fig 7).

Fig. 7: SDS PAGE of haemolymph of snail and crab
DISCUSSION
The pharmacological potential utilization of natural products have great attention due to the bioactivity nature of those products. The homeopathic medicines used by people are prepared mainly from plant or animal origin. Recently, the marine organisms attract the attention of researchers due to the presence of pharmacologically active drug and some of these active drugs has been identified and characterized [12]. Even though molluscs are widely used for various studies in research institutions, the antibacterial and antifungal nature of the substances was identified only in the recent years. It has been reported that the haemolymph of several molluscan species such as, sea hares, sea slung, oysters, and mussels has antibacterial and antiviral activities [13, 14, 15, 16].
The benthic invertebrates are potentially vulnerable to microbial infection, which may have led to evolution of chemical defense mechanisms. Most of the work carried out on antimicrobial compounds from freshwater bivalves deals with Pomacea insularium and Callinectes sapidus[17, 18]. Presuming that the antimicrobial compounds were either protein in nature or a combination of ‘Soft techniques’ was selected for the preparation of crude methanol, di-ethyl ether and water to ensure that the functionally and / or the biological activity of the analytes remained intact [19].
The reports of Periyasamy et al. [20] revealed that, the crude ethanol extracts of B. spirata showed good activities against Pseudomonas aeruginosa. According to Srinivasan [21] results, the methanol extract of Hemifusus pugilinus possessed the highest activity against E. coli. The lowest activity was recorded against Klebsiella oxytoca. The methanolic extract of chicoreus virgineus and C. ramous were experimentally analyzed by Sathana Ramasamy and Murugan [22] and they observed the broad spectrum antimicrobial activities of body tissue extract. According to Anand and Edward [23] the crude methanol extracts of Cypraea errones exhibited higher antibacterial and antifungal activities. The observed result clearly indicates that the methanol extracts of gastropods shows predominant activity against microbial pathogens. The knowledge of the self-defense mechanism of molluscs is extremely limited compared to that of vertebrates and arthropods.
In this present study, methanol was selected as a suitable solvent as it gave good extraction efficiency. Most of the low molecular weight proteins/peptides (stable at room temperature) were extracted from it and an added advantage of allowing rapid sample concentration. Other solvent medium is di-ethyl ether as most of the active high molecular weight proteins and peptides are known to be extracted in it. The result of antimicrobial assay in the present study indicates that these extracts showed high antimicrobial activity against the tested pathogens. This result indicates that these procedures are capable of extracting the antimicrobial compound with relatively higher activity and without degrading the nature of the compound.
The methanol fraction of Pomacea insularium (snail) extraction showed best activity against bacterial strains. The maximum zone of inhibition was recorded in Streptococcus sp. (27.83±0.76 mm) and minimum zone of inhibition was observed in Proteus sp. (17.16±0.76 mm). The extract also showed significant activity against Klebsiella sp. and Salmonella sp. (20.16±0.76 and 20.0±0.5 mm). When the methanol fraction of Callinocts sapidus (Crab) extraction was checked for antimicrobial activity against bacterial strains, the maximum zone of inhibition was recorded in E. coli sp. (32.16±0.28 mm) and minimum zone of inhibition was observed in Aeromonas sp. and Proteus sp. (18.0±0.5 mm). The antimicrobial activity of diethyl ether extract of Pomacea insularium was very effective against Streptococcus sp. (37.16±0.76 mm) and the minimum zone of inhibition was observed in Bacillus sp. (20.33±0.57 mm). When the antimicrobial activities of diethyl ether extract of Callinocts sapidus (Crab) was observed, the maximum activity was against Pseudomonas sp. (31.16±0.76 mm) and the minimum zone of inhibition was observed in Klebsiella sp. (17.33±0.28 mm). The antimicrobial activity against Aeromonas sp. and Bacillus sp. was found to be 21.16±0.28 mm. Similar result was reported by Premanand et al. [24] and Jayaseli et al. [25] who stated that the methanol and diethyl ether extracts of molluscs effectively inhibits the bacterial pathogens.
The antimicrobial activity of water extracts of Pomacea insularium was observed and the maximum activity was found against Proteus sp. (30.16±0.76 mm). Very similar to this, maximum antibacterial activity against Klebsiella sp. and Enterobacter sp. (20 mm) was reported by Mary Elezabeth et al. [26]. The maximum antimicrobial activity of water extracts of Callinocts sapidus (Crab) was against Pseudomonas sp. and Klebsiella sp. (23.16±0.28 mm and 22.83±0.28 mm respectively). The minimum zone of inhibition was observed in E. coli sp. (15.83±0.76 mm) and the study correlates with the results of Premanand et al. [24]. The extract also showed effective zone of inhibition against Aeromonas sp. (22 mm) and Bacillus sp. (20.5±0.86 mm) which correlates with the reports of Mary et al. [26]. Many of the organisms have antimicrobial properties, although most of the antibacterial agents that have been isolated from fresh water sources are not active enough to compete with classical antimicrobial obtained from organisms [27]. Pomacea insularium and Callinocts sapidus extraction that showed antimicrobial activity was subjected to SDS-PAGE to estimate the number and molecular weight of protein present. After electrophoresis clear band were detected in the gel which represented proteins of molecular weight nearly 110 kda. Although different species and experimental procedures were used in the different studies, they indicated the high frequency of detectable antimicrobial activity in marine molluscs. In the present study, it has been recorded that, a wide spectrum of antibacterial activity is found in almost all the solvents tested and these results indicates that cephalopods were good source for the search of new substances for drug development.
CONCLUSION
This research was schemed by the screening tactics based on the ecological knowledge of aquatic organisms being increasing by deployed in the investigation of novel bioactive compounds. However, the result presented here indicates that fresh water molluscus show antimicrobial properties against pathogens. The present study reports the effective antimicrobial activity of Pomacea insularium and Callinocts sapidus against various bacterial pathogens. From this study, we conclude that the haemolymph and the whole animal can be used as an antimicrobial agent for many different pathogens.
CONFLICT OF INTEREST
Declared None
REFERENCES